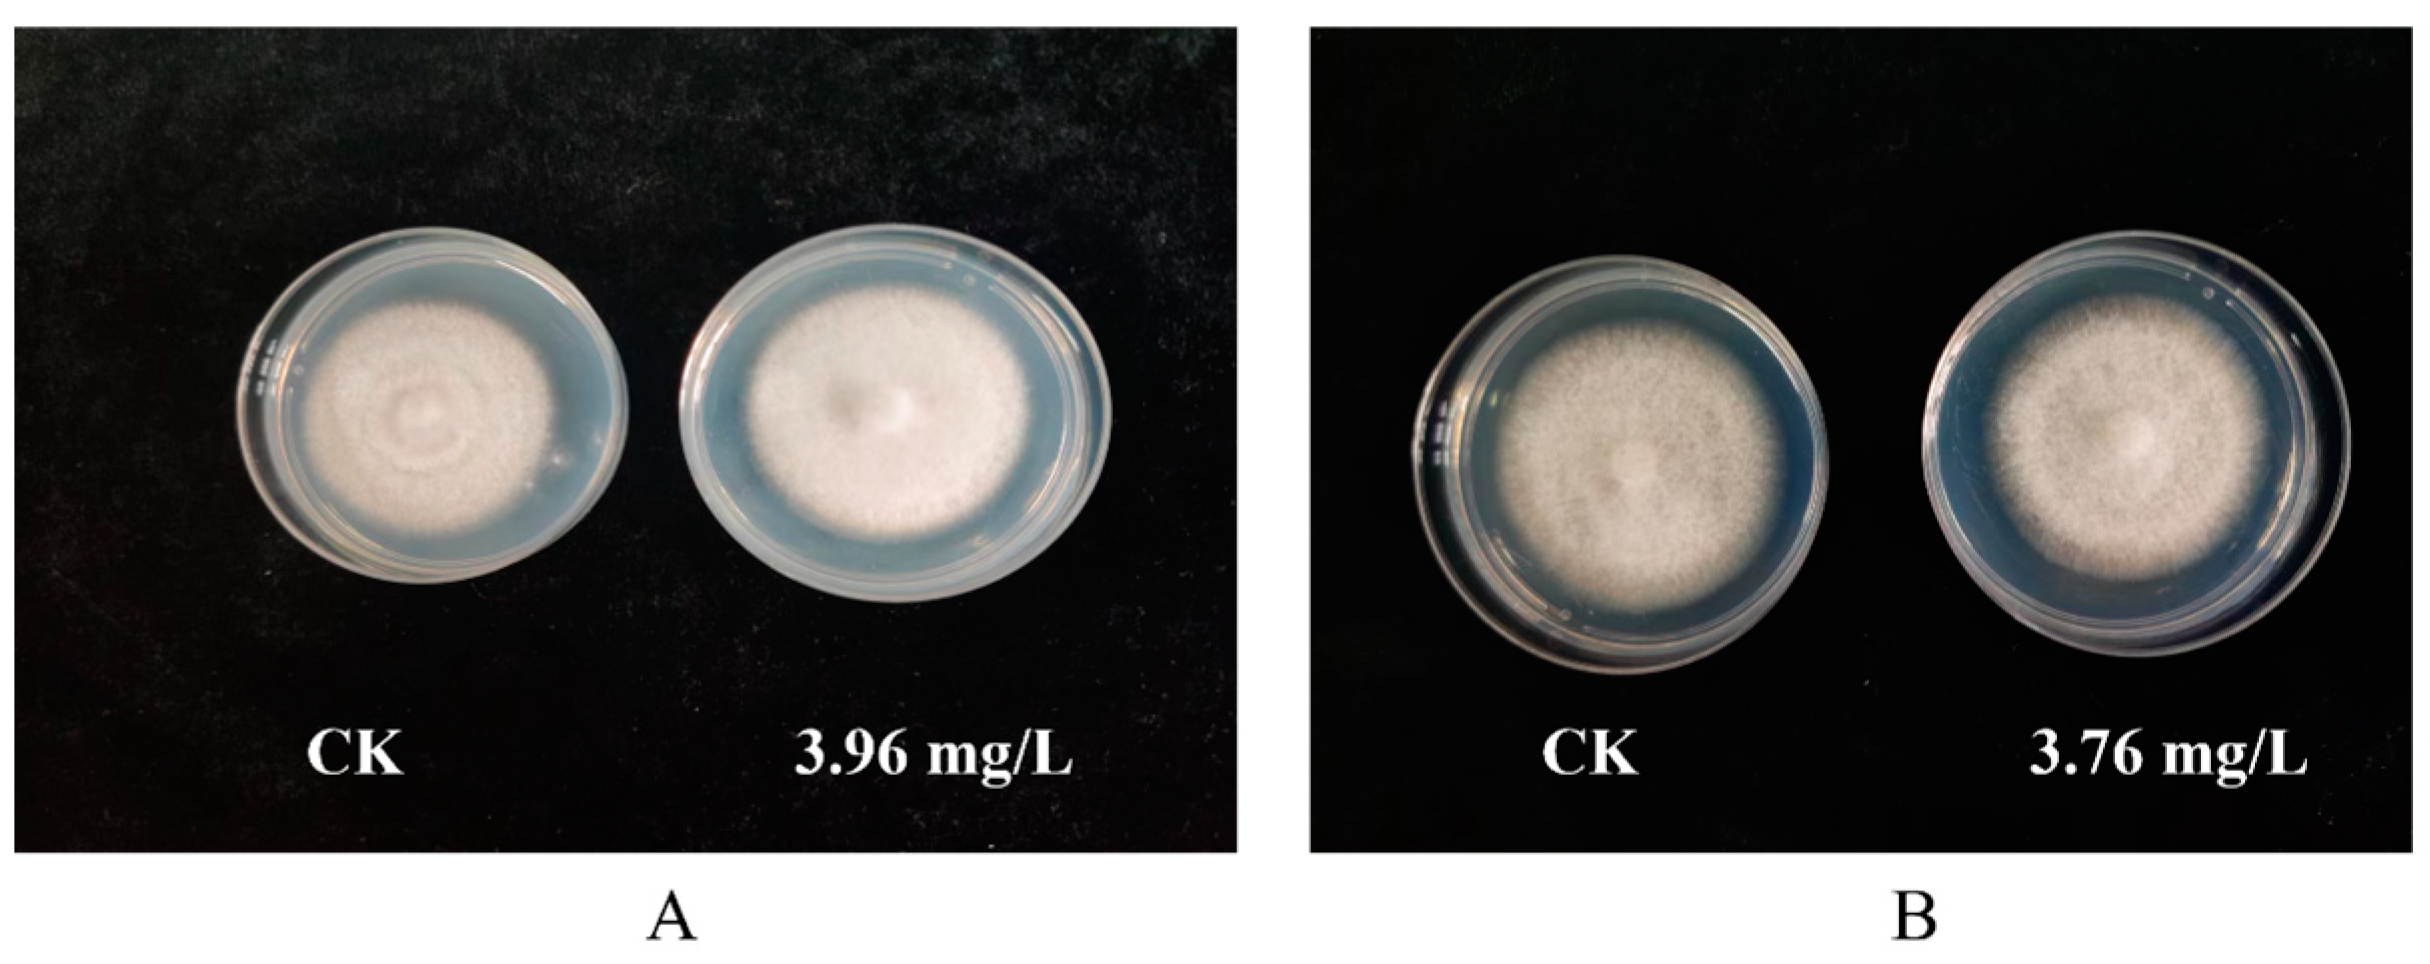
Jof 10 00676 g003

Evaluating Two Fungicides, Prochloraz–Manganese Chloride Complex and Seboctylamine Acetate, to Control Cobweb Disease in White Button Mushroom Caused by Cladobotryum mycophilum
Abstract
1. Introduction
2. Materials and Methods
2.1. Test Strains and Fungicides
2.2. Toxicity Measurement
action)/Pathogen diameter in control] × 100.
2.3. Spore Germination Test
treatment group)/spore germination rate of control group × 100%
2.4. Effect of Fungicides on Mycelial Growth of A. bisporus
action)/Pathogen diameter in control] × 100.
2.5. Field Safety of Fungicides on A. bisporus
2.6. Field Control Efficacy
2.7. Effect of Fungicides on the Yield of A. bisporus
2.8. Drug Residue Test
2.9. Statistical Analysis
3. Results
3.1. Toxicity Measurement
3.2. Spore Germination Test
3.3. Safety Test
3.4. Control Effect of Prochloraz–Manganese Chloride Complex and Seboctylamine Acetate Against Cobweb Disease in A. bisporus
3.5. Effects of Prochloraz–Manganese Chloride Complex and Seboctylamine Acetate Against Yield in A. bisporus
3.6. Effects of Prochloraz–Manganese Chloride Complex and Seboctylamine Acetate on Pesticide Residues in A. bisporus
4. Discussion
5. Conclusions
Author Contributions
Funding
Institutional Review Board Statement
Informed Consent Statement
Data Availability Statement
Conflicts of Interest
References
- Kumar, H.; Bhardwaj, K.; Kuča, K.; Sharifi Rad, J.; Verma, R.; Machado, M.; Kumar, D.; Cruz Martins, N. Edible mushrooms’ enrichment in food and feed: A mini review. Int. Food Sci. Technol. 2022, 53, 1386–1398. [Google Scholar] [CrossRef]
- Hou, X.; Luo, C.; Chen, S.; Jiang, J.; Yang, Z.; Wang, F.; Xie, X. Progress in research on diseases of edible fungi and their detection methods: A review. Crop Prot. 2023, 174, 106420. [Google Scholar] [CrossRef]
- Bellettini, M.; Bellettini, S.; Fiorda, F.; Pedro, A.; Bach, F.; Morón, M.; Ribani, R. Diseases and pests noxious to Pleurotus spp. mushroom crops. Rev. Argent. Microbiol. 2018, 50, 216–226. [Google Scholar] [CrossRef] [PubMed]
- Chen, M.; Liao, J.; Li, H.; Cai, Z.; Guo, Z.; Wach, M.; Wang, Z. iTRAQ-MS/MS proteomic analysis reveals differentially expressed proteins during post-harvest maturation of the white button mushroom Agaricus bisporus. Curr. Microbiol. 2017, 74, 641–649. [Google Scholar] [CrossRef] [PubMed]
- Oke, F.; Aslim, B. Protective effect of two edible mushrooms against oxidative cell damage and their phenolic composition. Food Chem. 2011, 128, 613–619. [Google Scholar] [CrossRef]
- Wu, J.; Wang, R.; Liu, X.; Ni, Y.; Sun, H.; Deng, X.; Wan, L.; Liu, F.; Tang, J.; Yu, J.; et al. Calcium dynamics during the growth of Agaricus bisporus: Implications for mushroom development and nutrition. Chem. Biol. Technol. Agric. 2023, 10, 99. [Google Scholar] [CrossRef]
- Han, J.; Jiang, X.; Feng, L.; Wang, J.; Wang, X.; Zhou, Q.; Kitazawa, H.; Guo, Y.; Li, L. Identification of Trichderma harzianum in postharvest Agaricus bisporus and a novel control approach using eucalyptus essential oil emulsion. Sci. Hortic. 2024, 329, 113029. [Google Scholar] [CrossRef]
- Xue, Y.; Xie, J.; Xu, X.; Yong, L.; Hu, B.; Liang, J.; Li, X.; Qing, L. UPLC-QqQ/MS combined with similarity assessment of 17 nucleic acid constituents in 147 edible fungi from Sichuan Basin, China. Food Res. Int. 2019, 120, 577–585. [Google Scholar] [CrossRef]
- Zhang, G.; Tang, C. First report of Acrostalagmus luteo-albus causing red rust of needle mushroom (Flammulina velutipes) in China. Plant Dis. 2015, 99, 158. [Google Scholar] [CrossRef]
- Umar, M.; Van Griensven, L. Studies on the morphogenesis of Agaricus bisporus: The dilemma of normal versus abnormal fruit body development. Mycol. Res. 1999, 103, 1235–1244. [Google Scholar] [CrossRef]
- Lan, Y.; An, X.; Wang, Q.; Tang, L. Study on biological characteristics of A. bisporus cobweb disease. Edible Fungi China 2017, 36, 62–65. [Google Scholar]
- Dhawan, A.; Chakraborty, S. Pulsed light treatment of whole white button mushroom (Agaricus bisporus): Kinetics and mechanism of microbial inactivation and storage study. J. Food Sci. 2024, 89, 5319–5334. [Google Scholar] [CrossRef] [PubMed]
- Navarro, J.; Carrasco, J.; González, A.; Suz, L. First report of cobweb on white button mushroom (Agaricus bisporus) in Spain caused by Cladobotryum mycophilum. Plant Dis. 2012, 96, 1067. [Google Scholar] [PubMed]
- Gea, F.; Navarro, M.; Suz, L.M. First report of cobweb disease caused by Cladobotryum dendroides on shiitake mushroom (Lentinula edodes) in Spain. Plant Dis. 2018, 102, 1030–1031. [Google Scholar] [CrossRef]
- Sossah, F.; Liu, Z.; Yang, C.; Okorley, B.; Sun, L.; Fu, Y.; Li, Y. Genome sequencing of Cladobotryum protrusum provides insights into the evolution and pathogenic mechanisms of the cobweb disease pathogen on cultivated mushroom. Genes 2019, 10, 124. [Google Scholar] [CrossRef] [PubMed]
- Bian, Y.; Xiao, Y.; Guo, M.P. Research progress on prevention and control of edible fungi diseases. Acta Edulis Fungi 2021, 28, 121–131. [Google Scholar]
- Lan, Y.; Wang, Q.; Yu, C.; Cong, Q.; Tang, L.; An, X.; Kong, F.; Li, X. First Report of Cladobotryum mycophilum Causing Cobweb Disease on Agaricus bisporus in China. Plant Dis. 2016, 100, 2334. [Google Scholar] [CrossRef]
- Shi, N.; Ruan, H.; Jie, Y.; Chen, F.; Du, Y. Sensitivity and efficacy of fungicides against wet bubble disease of Agaricus bisporus caused by Mycogone perniciosa. Eur. J. Plant Pathol. 2020, 157, 873–885. [Google Scholar] [CrossRef]
- Du, Y.; Shi, N.; Ruan, H.; Miao, J.; Yan, H.; Shi, C.; Chen, F.; Liu, X. Analysis of the prochloraz-Mn resistance risk and its molecular basis in Mycogone rosea from Agaricus bisporus. Pest Manag. Sci. 2021, 77, 4680–4690. [Google Scholar] [CrossRef]
- Chakwiya, A.; van der Linde, E.J.; Korsten, L. In vitro sensitivity testing of Cladobotryum mycophilum to carbendazim and prochloraz manganese. S. Afr. J. Sci. 2015, 111, 1–7. [Google Scholar] [CrossRef][Green Version]
- Luković, J.; Potočnik, I.; Šantrić, L.; Radivojević, L.; Todorović, B.; Milijašević-Marčić, S.; Szűcs, A.; Kredics, L.; Vágvölgyi, C.; Hatvani, L. Response of the mushroom pathogen Cladobotryum mycophilum to prochloraz and metrafenone fungicides and Streptomyces flavovirens actinobacteria. J. Environ. Sci. Health B 2022, 57, 636–643. [Google Scholar] [CrossRef] [PubMed]
- Clarke, J.; McGuinness, B.; Fitzpatrick, D.; Kavanagh, K.; Grogan, H. Response of the mushroom pathogen Cladobotryum mycophilum to the fungicides prochloraz and metrafenone and two Bacillus-based biological control agents in mushroom crop trials. Crop Prot. 2024, 177, 106530. [Google Scholar] [CrossRef]
- Grogan, H. Fungicide control of mushroom cobweb disease caused by Cladobotryum strains with different benzimidazole resistance profiles. Pest Manag. Sci. 2006, 2, 153–161. [Google Scholar] [CrossRef] [PubMed]
- Qin, G.; Chen, Y.; He, F.; Yang, B.; Zou, K.; Shen, N.; Zuo, B.; Liu, R.; Zhang, W.; Li, Y. Risk assessment of fungicide pesticide residues in vegetables and fruits in the mid-western region of China. J. Food Compos. Anal. 2021, 95, 103663. [Google Scholar] [CrossRef]
- Marquette, C.; Blum, L.J. Applications of the luminol chemiluminescent reaction inanalytical chemistry. Anal. Bioanal. Chem. 2006, 385, 546–554. [Google Scholar] [CrossRef] [PubMed]
- Guo, S.J.; Zhang, C.C.; Li, B.; Zhang, F.; Han, J.; Chen, X.; Su, X.F.; Sun, J.H.; Feng, J.L. Simultaneous determination of quaternary phosphonium compounds and phosphine oxides in environmental water and solid samples by ultrahigh performance liquid chromatography–tandem mass spectrometry. J. Chromatogr. A 2024, 1733, 465280. [Google Scholar] [CrossRef]
- AI-Amoud, A.; Clark, B.; Chrystyn, H. Determinationof gentamicin in urine samples after inhalation by reversed-phase high-performance liquid chromatography using pre-column derivatisation with o-phthalaldehyde. J. Chromatogr. B 2002, 769, 89–95. [Google Scholar] [CrossRef]
- Chen, Q.; Qiu, Y.; Yuan, Y.; Wang, K.; Wang, H. Biocontrol activity and action mechanism of Bacillus velezensis strain SDTB038 against Fusarium crown and root rot of tomato. Front. Microbiol. 2022, 13, 994716. [Google Scholar] [CrossRef]
- Qiu, Y.; Yan, H.; Sun, S.; Wang, Y.; Zhao, X.; Wang, H. Use of Bacillus velezensis SDTB022 against tobacco black shank (TBS) and the biochemical mechanism involved. Biol. Control 2022, 165, 104785. [Google Scholar] [CrossRef]
- Gao, Y.; He, L.; Li, B.; Mu, W.; Lin, J.; Liu, F. Sensitivity of Colletotrichum acutatum to six fungicides and reduction in incidence and severity of chili anthracnose using pyraclostrobin. Australas. Plant Pathol. 2017, 46, 521–528. [Google Scholar] [CrossRef]
- Yang, X.; Deng, P.; Liu, Q.; Meng, Y.; Dong, P.; Xu, L.; Huang, L. Exploring the efficacy of carvacrol as a biocontrol agent against pear Valsa canker. Pestic. Biochem. Phys. 2023, 196, 105641. [Google Scholar] [CrossRef] [PubMed]
- Chen, Q.; Gao, J.; Yang, X.; Qiu, X.; Wang, Y.; Wang, H. Synergistic effects of Bacillus velezensis SDTB038 and phenamacril on Fusarium crown and root rot of tomato. Plant Pathol. 2023, 72, 1453–1462. [Google Scholar] [CrossRef]
- Fang, Q.; Yao, G.; Shi, Y.; Ding, C.; Wang, Y.; Wu, X.; Hua, R.; Cao, H. Residue dynamics and risk assessment of prochloraz and its metabolite 2,4,6-trichlorophenol in apple. Molecules 2017, 22, 1780. [Google Scholar] [CrossRef] [PubMed]
- NY/T 1965.1-2010; Guidelines for Crop Safety Evaluation of Pesticides. Part 1: Laboratory Test for Crop Safety Evaluation of Fungicides and Insecticides. Ministry of Agriculture, Pesticide Testing Center: Beijing, China, 2010.
- NY/T 1464.10-2007; Guidelines on Efficacy Evaluation of Pesticides. Part 10: Fungicides against wet Bubble Disease of Mushrooms. Ministry of Agriculture, Pesticide Testing Center: Beijing, China, 2007.
- Santana-Mayor, A.; Rodríguez-Ramos, R.; Herrera-Herrera, A.; Socas-Rodríguez, B.; Rodríguez-Delgadoet, M. Updated overview of QuEChERS applications in food, environmental and biological analysis (2020–2023). TrAC Trend Anal. Chem. 2023, 169, 117375. [Google Scholar] [CrossRef]
- Qin, Y.; Liu, D.; Wu, Y.; Yuan, M.; Li, L.; Yang, J. Effect of PLA/PCL/cinnamaldehyde antimicrobial packaging on physicochemical and microbial quality of button mushroom (Agaricus bisporus). Postharvest Biol. Technol. 2015, 99, 73–79. [Google Scholar] [CrossRef]
- Wang, T.; Yun, J.; Zhang, Y.; Bi, Y.; Zhao, F.; Niu, Y. Effects of ozone fumigation combined with nano-film packaging on the postharvest storage quality and antioxidant capacity of button mushrooms (Agaricus bisporus). Postharvest Biol. Technol. 2021, 176, 111501. [Google Scholar] [CrossRef]
- Carrasco, J.; Navarro, M.; Santos, M.; Gea, F. Effect of five fungicides with different modes of action on cobweb disease (Cladobotryum mycophilum) and mushroom yield. Ann. Appl. Biol. 2017, 171, 62–69. [Google Scholar] [CrossRef]
- Stanojević, O.; Berić, T.; Potočnik, I.; Rekanović, E.; Stanković, S.; Milijašević-Marčić, S. Biological control of green mould and dry bubble diseases of cultivated mushroom (Agaricus bisporus L.) by Bacillus spp. Crop Protect. 2019, 126, 104944. [Google Scholar] [CrossRef]
- Gea, F.J.; Navarro, M.J.; Santos, M.; Diánez, F.; Carrasco, J. Control of fungal diseases in mushroom crops while dealing with fungicide resistance: A Review. Microorganisms 2021, 9, 585. [Google Scholar] [CrossRef]
- Bhat, A.; Bhat, Z.; Khan, N.; Mohiddin, F.; Mir, G. Response of fungicides against Verticillium fungicola and the host fungus Agaricus bisporus under in vitro conditions. Pestic. Res. J. 2017, 29, 6–11. [Google Scholar]
- Liu, C.; Sheng, J.; Chen, L.; Zheng, Y.; David, Y.; Yang, Y.; Xu, M.; Shen, L. Biocontrol activity of Bacillus subtilis isolated from Agaricus bisporus mushroom compost against pathogenic fungi. J. Agric. Food Chem. 2015, 63, 6009–6018. [Google Scholar] [CrossRef] [PubMed]
- Clarke, J.; Grogan, H.; Fitzpatrik, D.; Kavanagh, K. Analysis of the effect of Bacillus velezensis culture filtrate on the growth and proteome of Cladobotryum mycophilum. Fungal Biol. 2022, 126, 11–19. [Google Scholar] [CrossRef] [PubMed]
- Largeteau, M.; Savoie, J. Microbially induced diseases of Agaricus bisporus: Biochemical mechanisms and impact on commercial mushroom production. Appl. Microbiol. Biot. 2010, 86, 63–73. [Google Scholar] [CrossRef] [PubMed]
- Diamantopoulou, P.; Philippoussis, A.; Kastanias, M.; Flouri, F.; Tokousbalides, M. Effect of famoxadone, tebuconazole and trifloxystrobin on Agaricus bisporus productivity and quality. Sci. Hortic. 2006, 109, 190–195. [Google Scholar] [CrossRef]
- Schusterova, D.; Mraz, P.; Uttl, L.; Drabova, L.; Kocourek, V.; Hajslova, J. Pesticide residues in fresh and processed edible mushrooms from Czech markets. Food Addit. Contam. B. 2023, 16, 384–392. [Google Scholar] [CrossRef]
- Maron, D.; Smith, T.; Nachman, K. Restrictions on antimicrobial use in food animal production: An international regulatory and economic survey. Glob. Health 2013, 9, 1–11. [Google Scholar] [CrossRef]
- Han, C.; Hu, B.; Chen, S.; Wang, N.; Hou, J.; Jin, N.; Shen, Y. Determination of Xinjunan pesticide residue in foodstuffs of plant origin by a modified QuEChERS method and ultra performance liquid chromatography-tandem mass spectrometry. LWT 2021, 151, 112101. [Google Scholar] [CrossRef]
- Zheng, X.; Xu, J.; Sun, H. Study on the analysis method of prochloraz-manganese chloride complex 50% wettable powder in grape and soil by high performance liquid chromatography. Pestic. Sci. Adm. 2014, 35, 38–41. [Google Scholar]

| Fungicide | Experimental Chemical Concentration (mg/L) |
|---|---|
| Quatrimycin | 0.075, 0.150, 0.300, 0.600, 1.200, 2.400, 4.800 |
| Prochloraz–manganese chloride complex | 0.150, 0.300, 0.600, 1.200, 2.400, 4.800, 9.600 |
| Seboctylamine acetate | 0.196, 0.391, 0.781, 1.563, 3.125, 6.250, 12.500 |
| Prothioconazole | 0.075, 0.150, 0.300, 0.600, 1.200, 2.400, 4.800 |
| Tebuconazole | 0.150, 0.300, 0.600, 1.200, 2.400, 4.800, 9.600 |
| Difenoconazole | 0.781, 1.563, 3.125, 6.250, 12.500, 25.000, 50.000 |
| Pyrimethanil | 6.250, 12.500, 25.000, 50.000, 100.000, 200.000 |
| Kresoxim-methyl | 6.250, 12.500, 25.000, 50.000, 100.000, 200.000 |
| Polyoxin | 0.781, 1.563, 3.125, 6.250, 12.500, 25.000, 50.000 |
| Fungicide | Experimental Chemical Concentration (mg/L) |
|---|---|
| Quatrimycin | 0.150, 0.300, 0.600, 1.200, 2.400, 4.800, 9.600 |
| Prochloraz–manganese chloride complex | 2.000, 4.000, 8.000, 16.000, 32.000, 64.000, 128.000 |
| Seboctylamine acetate | 0.075, 0.150, 0.300, 0.600, 1.200, 2.400, 4.800 |
| Prothioconazole | 2.000, 4.000, 8.000, 16.000, 32.000, 64.000, 128.000 |
| Tebuconazole | 0.150, 0.300, 0.600, 1.200, 2.400, 4.800, 9.600 |
| Difenoconazole | 2.000, 4.000, 8.000, 16.000, 32.000, 64.000, 128.000 |
| Pyrimethanil | 1.000, 2.000, 4.000, 8.000, 16.000, 32.000, 64.000 |
| Kresoxim-methyl | 2.000, 4.000, 8.000, 16.000, 32.000, 64.000, 128.000 |
| Fungicides | Qualitative Ion Pair (m/z) | Quantitative Ion Pair (m/z) | DP (V) | CE (eV) | Retention Time (min) |
|---|---|---|---|---|---|
| Seboctylamine acetate | 328.5/199.2 | 328.5/156.2 | 166 | 25/35 | 3.080 |
| Prochloraz–manganese chloride complex | 376.0/308.0 | 376.0/266.0 | 42 | 8/16 | 3.820 |
| Fungicides | Regression Equation | Coefficient of Determination | EC50/(mg·L−1) | 95% Confidence Interval |
|---|---|---|---|---|
| Quatrimycin | y = 0.803 + 1.409x | 0.927 | 0.269 | 0.095~0.582 |
| Prochloraz–manganese chloride complex | y = 0.027 + 1.002x | 0.932 | 0.939 | 0.171~3.093 |
| Seboctylamine acetate | y = 0.006 + 1.645x | 0.968 | 0.991 | 0.367~2.696 |
| Prothioconazole | y = 0.820 + 1.324x | 0.809 | 0.240 | 0.001~0.574 |
| Tebuconazole | y = −0.150 + 0.956x | 0.864 | 1.435 | 0.426~12.328 |
| Difenoconazole | y = −0.585 + 0.714x | 0.892 | 6.589 | - |
| Pyrimethanil | y = −2.077 + 1.350x | 0.663 | 34.584 | 15.469~324.450 |
| Kresoxim-methyl | y = −1.843 + 1.233x | 0.773 | 31.271 | 13.563~340.752 |
| Polyoxin | y = −1.044 + 1.623x | 0.623 | 4.396 | 1.129~19.953 |
| Fungicides | Regression Equation | Coefficient of Determination | EC50/(mg·L−1) | 95% Confidence Interval |
|---|---|---|---|---|
| Prochloraz–manganese chloride complex | y = −1.958 + 1.027x | 0.677 | 80.588 | 55.482~125.775 |
| Seboctylamine acetate | y = 0.264 + 1.417x | 0.845 | 0.652 | 0.509~0.824 |
| Prothioconazole | y = −3.636 + 2.216x | 0.38 | 43.766 | 24.923~91.635 |
| Pyrimethanil | y = −1.564 + 1.388x | 0.506 | 13.393 | 7.598~21.968 |
| Difenoconazole | y = −2.025 + 1.203x | 0.824 | 48.227 | 32.280~85.313 |
| Kresoxim-methyl | y = −3.191 + 1.816x | 0.5 | 57.117 | 31.357~276.730 |
| Tebuconazole | y = −1.346 + 2.86x | 0.912 | 0.338 | 0.295~0.387 |
| Quatrimycin | y = −1.563 + 1.970x | 0.933 | 1.365 | 0.897~3.652 |
| Fungicides | Effective Concentration/(mg·L−1) | A. bisporus W2000 | A. bisporus W192 | A. bisporus S2796 | |||
|---|---|---|---|---|---|---|---|
| Colony Diameter/(cm) | Inhibition Ratio | Colony Diameter /(cm) | Inhibition Ratio | Colony Diameter/(cm) | Inhibition Ratio | ||
| CK | - | 6.43 ± 0.17 a | - | 6.52 ± 0.18 a | - | 6.51 ± 0.16 a | - |
| Prochloraz–manganese chloride complex | 0.94 | 6.28 ± 0.05 ab | 0.02 | 6.41 ± 0.06 a | 0.02 | 6.23 ± 0.05 bcd | 0.04 |
| 1.88 | 6.25 ± 0.03 ab | 0.03 | 6.35 ± 0.06 a | 0.03 | 6.17 ± 0.06 cd | 0.05 | |
| 3.76 | 6.13 ± 0.04 b | 0.05 | 6.33 ± 0.06 a | 0.03 | 6.14 ± 0.06 d | 0.06 | |
| Seboctylamine acetate | 0.99 | 6.32 ± 0.05 ab | 0.02 | 6.39 ± 0.07 a | 0.02 | 6.39 ± 0.05 abcd | 0.02 |
| 1.98 | 6.26 ± 0.07 ab | 0.03 | 6.37 ± 0.07 a | 0.02 | 6.26 ± 0.10 abcd | 0.04 | |
| 3.96 | 6.22 ± 0.07 ab | 0.03 | 6.29 ± 0.10 a | 0.04 | 6.25 ± 0.09 abcd | 0.04 | |
| Fungicides | Effective Concentration/(mg·L−1) | Yield/(g) |
|---|---|---|
| CK | - | 529.3 ± 21.7 a |
| Prochloraz–manganese chloride complex | 400 | 519.9 ± 3.4 a |
| 800 | 502.1 ± 10.4 a | |
| 1600 | 492.6 ± 3.6 a | |
| Seboctylamine acetate | 6 | 493.0 ± 3.9 a |
| 12 | 527.5 ± 10.0 a | |
| 24 | 530.0 ± 16.6 a |
| Fungicides | Experimental Chemical Concentration/(mg·L−1) | Incidence/(%) | Control Effect/(%) |
|---|---|---|---|
| CK | - | 61.0 | - |
| Prochloraz–manganese chloride complex | 400 | 29.4 | 49.41 ± 6.35 d |
| 800 | 26.6 | 54.11 ± 5.69 d | |
| 1600 | 22.4 | 61.38 ± 4.63 c | |
| Seboctylamine acetate | 2 | 16.7 | 71.76 ± 3.65 b |
| 4 | 12.4 | 78.82 ± 2.89 a | |
| 6 | 10.9 | 81.17 ± 6.51 a |
Disclaimer/Publisher’s Note: The statements, opinions and data contained in all publications are solely those of the individual author(s) and contributor(s) and not of MDPI and/or the editor(s). MDPI and/or the editor(s) disclaim responsibility for any injury to people or property resulting from any ideas, methods, instructions or products referred to in the content. |
© 2024 by the authors. Licensee MDPI, Basel, Switzerland. This article is an open access article distributed under the terms and conditions of the Creative Commons Attribution (CC BY) license (https://creativecommons.org/licenses/by/4.0/).
Share and Cite
Chen, Q.; Yuan, Y.; Chen, G.; Li, N.; Li, X.; Lan, Y.; Wang, H. Evaluating Two Fungicides, Prochloraz–Manganese Chloride Complex and Seboctylamine Acetate, to Control Cobweb Disease in White Button Mushroom Caused by Cladobotryum mycophilum. J. Fungi 2024, 10, 676. https://doi.org/10.3390/jof10100676
Chen Q, Yuan Y, Chen G, Li N, Li X, Lan Y, Wang H. Evaluating Two Fungicides, Prochloraz–Manganese Chloride Complex and Seboctylamine Acetate, to Control Cobweb Disease in White Button Mushroom Caused by Cladobotryum mycophilum. Journal of Fungi. 2024; 10(10):676. https://doi.org/10.3390/jof10100676
Chicago/Turabian StyleChen, Qiqi, Yazhen Yuan, Gang Chen, Ning Li, Xinrong Li, Yufei Lan, and Hongyan Wang. 2024. "Evaluating Two Fungicides, Prochloraz–Manganese Chloride Complex and Seboctylamine Acetate, to Control Cobweb Disease in White Button Mushroom Caused by Cladobotryum mycophilum" Journal of Fungi 10, no. 10: 676. https://doi.org/10.3390/jof10100676
APA StyleChen, Q., Yuan, Y., Chen, G., Li, N., Li, X., Lan, Y., & Wang, H. (2024). Evaluating Two Fungicides, Prochloraz–Manganese Chloride Complex and Seboctylamine Acetate, to Control Cobweb Disease in White Button Mushroom Caused by Cladobotryum mycophilum. Journal of Fungi, 10(10), 676. https://doi.org/10.3390/jof10100676

